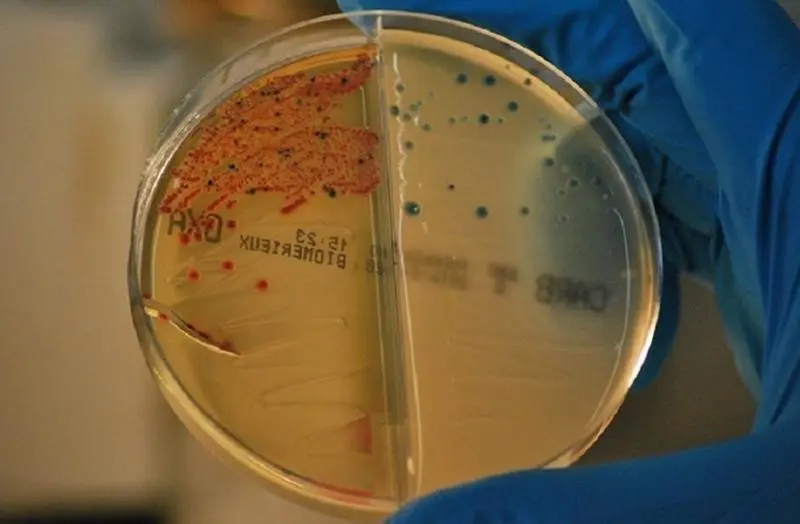
<p> Esta campa&ntilde;a ya ha usado el mismo eslogan otros a&ntilde;os, buscando siempre fomentar el uso responsable. </p>

"Antibióticos: Tomátelos en serio": Sanidad recupera la campaña para su uso responsable
Esta campaña, cuyo objetivo es concienciar sobre el uso responsable de estos medicamentos, tendrá el apoyo de varios anuncios televisivos a lo largo de este mes.
El Ministerio de Sanidad y la Agencia Española de Medicamentos y Productos Sanitarios (AEMPS) han lanzado la campaña publicitaria 'Antibióticos: tómatelos en serio', una nueva iniciativa del Plan Nacional frente a la Resistencia a los Antibióticos (PRAN) para la concienciación sobre la importancia del uso prudente de estos medicamentos.
La campaña se difundirá del 8 al 21 de noviembre con un anuncio de televisión que se emitirá en cadenas nacionales y autonómicas. Los materiales de esta iniciativa, que ha contado con un presupuesto aproximado de 500.000 euros, también se promoverán en redes sociales.
La difusión de esta campaña es una de las actividades programadas en el marco del Día Europeo para el Uso Prudente de los Antibióticos, que se celebra cada 18 de noviembre, y la Semana Mundial de Concienciación sobre el Uso de los Antibióticos (18-24 de noviembre).
La meta del 'spot' es concienciar sobre el riesgo que supone para la salud de todos el uso incorrecto de los antibióticos, uno de los principales motivos por los que se desarrollan y propagan las bacterias resistentes.
El mensaje principal subraya el error que supone utilizar antibióticos para tratar una infección de origen vírico como la gripe y lo hace comparando esta situación con otra que también resulta "absurda".
La nueva campaña utiliza un guion de tono humorístico que vuelve a subrayar que el uso de antibióticos frente a infecciones que no son de origen bacteriano constituye un comportamiento erróneo que pueden provocar el desarrollo de resistencia y comprometer, por tanto, la eficacia terapéutica de estos medicamentos en futuros tratamientos. Así, se destaca que los antibióticos sólo tratan infecciones bacterianas, no alivian el dolor ni la fiebre y deben utilizarse siempre bajo prescripción médica o veterinaria.
LA RESISTENCIA BACTERIANA EN ESPAÑA
El uso inadecuado o excesivo de los antibióticos es una de las causas fundamentales de la aparición y propagación de bacterias resistentes, uno de los mayores retos globales de la medicina moderna. Cada año 33.000 personas mueren en toda Europa como consecuencia de infecciones hospitalarias causadas por bacterias resistentes y, de acuerdo con los últimos datos, 4.000 de estas muertes se registran en España, cuatro veces más que las provocadas por accidentes de tráfico.
El conocimiento general de este problema ha mejorado en los últimos años. Según el último Eurobarómetro de la Comisión Europea, el porcentaje de españoles que piensa equivocadamente que los antibióticos curan el resfriado ha bajado desde el 45 (2016) al 36 por ciento (2018), uno de los mayores descensos registrados en la Unión Europea. Sin embargo, se mantiene en el 5 por ciento el porcentaje de españoles que reconoce automedicarse con antibióticos.
Para concienciar sobre la importancia del uso adecuado de estos medicamentos y poner en marcha medidas que contribuyan a frenar la resistencia, se puso en marcha en 2014 el Plan Nacional frente a la Resistencia a los Antibióticos (PRAN), promovido por el Ministerio de Sanidad junto con el Ministerio de Agricultura, Pesca y Alimentación y coordinado por la AEMPS con la participación de todas las comunidades autónomas y nueve ministerios (Sanidad, Agricultura, Economía, Interior, Defensa, Educación, Ciencia, Universidades y Transición Ecológica).
También en el marco del Día Europeo para el Uso Prudente de los Antibióticos y la Semana Mundial de Concienciación sobre el Uso de los Antibióticos, el PRAN organiza otra actividad que busca informar y concienciar: la Jornada del Día Europeo para el Uso Prudente de los Antibióticos el 18 de noviembre. Como cada año, durante esta jornada divulgativa varios expertos en diferentes áreas tratarán la actualidad del problema de la resistencia en España.





